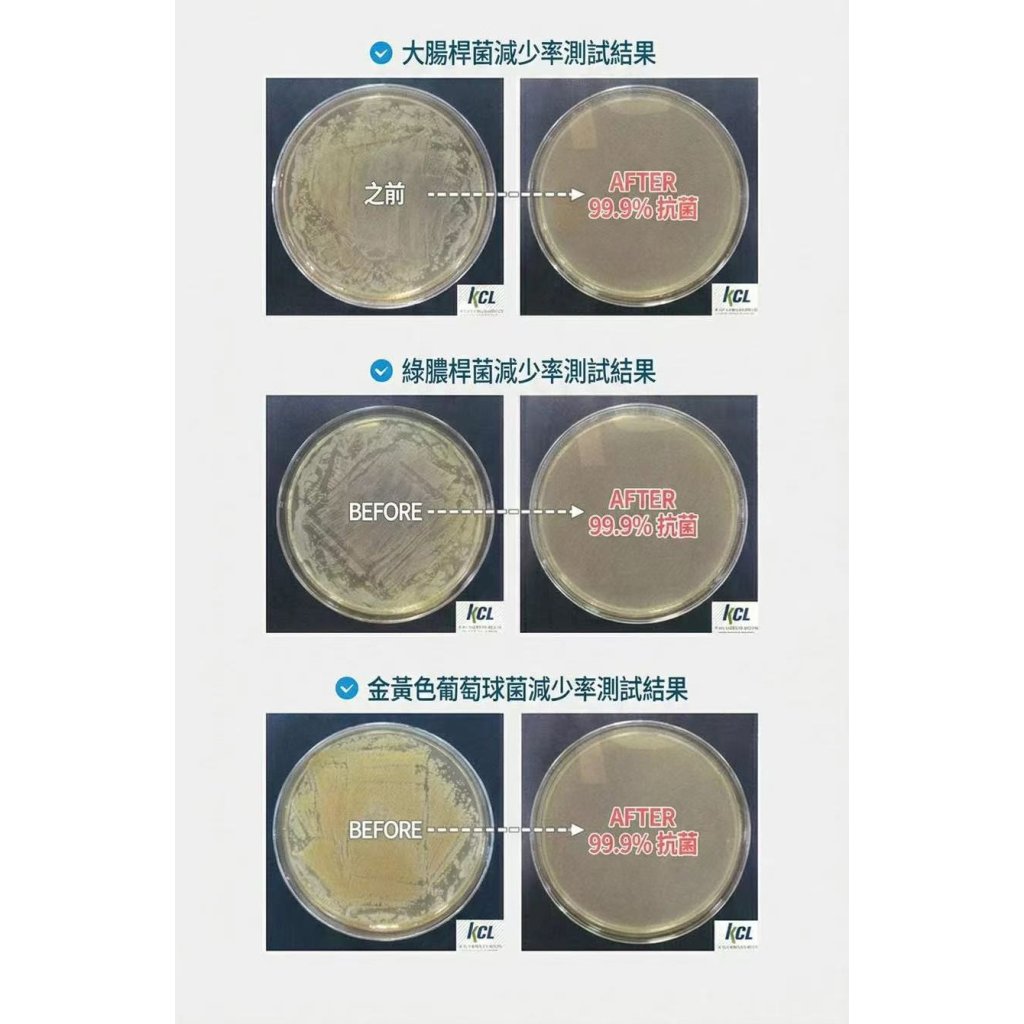

申 請 會 員 購 物,可 賺 購 物 金,下 張 單 使 用 ~24小時可自助下單喔!!購物滿$100可得到$1購物金
-
-
0我的購物車{{item.promotion_name}}{{ presentmentCurrencyPriceFormat(item.total_price_with_addon)}} {{ presentmentCurrencyPriceFormat(item.price * item.qty)}}{{ presentmentCurrencyPriceFormat(item.net_price * item.qty)}} {{ presentmentCurrencyPriceFormat(item.price * item.qty)}}{{item.name}} ({{item.variant_name}})數量: {{ item.qty }}小計:{{ presentmentCurrencyPriceFormat(cart['subtotal']) }}你的購物車沒有貨品。
主頁
韓國Atojet過濾花灑頭|明星JENNIE同款-改善水質-改善膚質
{{product['name']}}
重量: {{selected_product['weight']}}公斤
{{ isSelectedAllOptions ? presentmentCurrencyProductPriceRangeFormat(selected_product, 'original_price') : presentmentCurrencyProductPriceRangeFormat(product, 'original_price') }}
{{ isSelectedAllOptions ? presentmentCurrencyProductPriceRangeFormat(selected_product, 'price') : presentmentCurrencyProductPriceRangeFormat(product, 'price') }}
{{ps.product_series.display_name}}
{{ group.name }}
Required
{{ group.group_min_hints }}
{{ group.group_max_hints }}
{{ group.group_max_hints }}
銷售開始時間 : {{dateFormat(product.schedule_sell.pss_start_date, 'YYYY-MM-DD HH:mm')}}
銷售結束時間 : {{dateFormat(product.schedule_sell.pss_end_date, 'YYYY-MM-DD HH:mm')}}
{{product['negative_message']}}
{{product['negative_message']}}
描述
韓國大熱過濾花灑 Atojet 🚿終於登陸香港‼️,採用3重過濾系統,經實驗室測試有效減少細菌及殘留氯,改善膚質及髮質。超細微孔大大增加水壓,讓淋浴🛁更加舒適。另外可以加上專屬維他命淋浴過濾器,用水經過後增添維他命C及香氣,讓皮膚進一步得到營養,每天的淋浴也變成一種享受。
ATOJET | 家用蓮蓬頭 AJ-8200
✅3重過濾系統,去除鐵鏽、異物
✅抗菌99.9%,遠離細菌
✅有效改善膚質及髮質
✅採用FDA認證材料製成的安全過濾器
✅超細微孔增強水壓,邊用邊省水
✅100%韓國生產